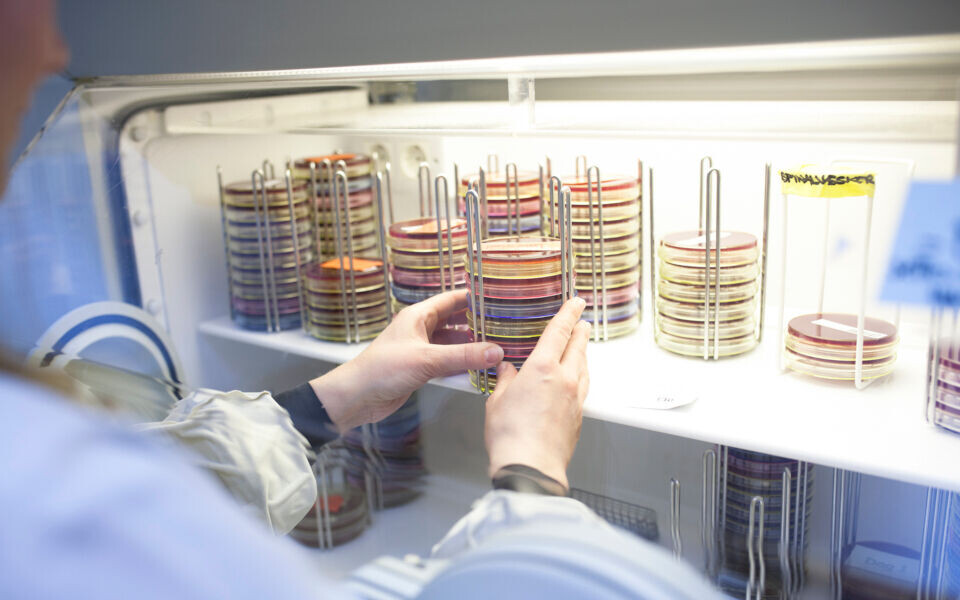

Debatt
Bioingeniørene trenger mer enn en treårig utdanning
Kommentar til fagstyremedlem Frode Vågens innlegg i Bioingeniøren nr. 5.
Av KAJA MARIENBORG, bioingeniør, Mikrobiologisk avdeling, Sykehuset i Vestfold
I artikkelen «Er kompetansen ved endt treårig bioingeniørutdanning god nok?» gir Frode Vågen uttrykk for at en treårig bioingeniørutdanning er nok til å møte kravene til bioingeniørfaglig kompetanse.
Han mener at dagens utdanning dekker tilstrekkelig alle de fagfelt bioingeniører skal dekke i sykehusets laboratorier, og at formidling av realkompetanse er godt nok for å kunne opprettholde videre kompetanseutvikling og møte nye faglige utfordringer.
Jeg mener han tar feil. Det er en gammeldags og snever holdning.
Flere fagområder er ikke godt nok ivaretatt
Bioingeniørenes utdanning er allerede fullpakket med fagkunnskap, og bioingeniørutdanningene må ta ganske krevende valg om hvor de legger sine prioriteringer. Det fører til en utdannelse med høyt fokus på medisinsk biokjemi.
Dette er forståelig når sikkert flere enn 60 prosent av bioingeniørene går til medisinsk biokjemi etter endt utdanning. Men fagområder som medisinsk mikrobiologi og molekylærbiologi er ikke godt nok ivaretatt. Dette er fag som er blitt betraktelig mer omfattende, og krever en større faglig orientering enn hva dagens utdanning makter å tilby i en allerede presset studieplan.
Realkompetanse er bra – men ikke nok
For å kunne jobbe selvstendig på et mikrobiologisk laboratorium kreves opptil et år med spesialistfaglig kompetanseheving. Da er vi ikke lenger «bare» bioingeniører som kan flyttes fritt mellom fagområdene. Da er vi bioingeniører med spesialkompetanse innen et ganske komplisert fagområde. Molekylærgenetikk er et fagområde som begynner å innta alle laboratoriefagene. Koronapandemien har også vist at det er ikke «bare» å sette opp en in-house-metode over natten, spesielt når du mangler fagkompetansen på avdelingen din.
Frode Vågen har rett i at formidling av realkompetanse er bra for å opprettholde kompetanse blant kolleger - og til dels også laboratoriekompetanse hos utdanningene. Samtidig er ikke dagens laboratoriehverdag slik at den ikke krever vitenskapelig formidling og kritisk tilnærming til forskningslitteratur. Å skaffe seg slik kompetanse krever mer enn treårig utdanning.